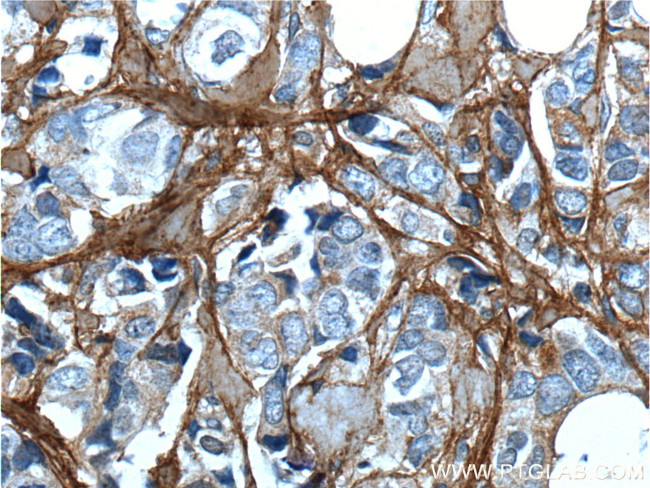
Periostin Antibody in Immunohistochemistry (Paraffin) (IHC (P))
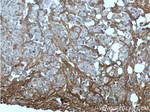
Periostin Antibody in Immunohistochemistry (Paraffin) (IHC (P))

Search
Proteintech
Periostin Polyclonal Antibody
{{$productOrderCtrl.translations['antibody.pdp.commerceCard.promotion.promotions']}}
{{$productOrderCtrl.translations['antibody.pdp.commerceCard.promotion.viewpromo']}}
{{$productOrderCtrl.translations['antibody.pdp.commerceCard.promotion.promocode']}}: {{promo.promoCode}} {{promo.promoTitle}} {{promo.promoDescription}}. {{$productOrderCtrl.translations['antibody.pdp.commerceCard.promotion.learnmore']}}
产品信息
19899-1-AP
种属反应
已发表种属
宿主/亚型
分类
类型
抗原
偶联物
形式
浓度
规格
纯化类型
保存液
内含物
保存条件
运输条件
产品详细信息
Immunogen sequence: ANNHYDKIL AHSRIRGRDQ GPNVCALQQI LGTKKKYFST CKNWYKKSIC GQKTTVLYEC CPGYMRMEGM KGCPAVLPID HVYGTLGIVG ATTTQRYSDA SKLREEIEGK GSFTYFAPSN EAWDNLDSDI RRGLESNVNV ELLNALHSHM INKRMLTKDL KNGMIIPSMY NNLGLFINHY PNGVVTVNCA RIIHGNQIAT NGVVHVIDRV LTQIGTSIQD FIEAEDDLSS FRAAAITSDI LEALGRDGHF TLFAPTNEAF EKLPRGVLER IMGDKVASEA LMKYHILNTL QCSESIMGGA VFETLEGNTI EIGCDGDSIT VNGIKMVNKK DIVTNNGVIH LIDQVLIPD (21-368 aa encoded by BC106710)
靶标信息
Periostin (PN), also designated osteoblast-specific factor 2 (OSF-2), is a disulfide linked protein originally isolated as a osteoblast-specific factor. Periostin is a secreted protein that binds heparin and functions as a ligand for alpha(V)beta(3) and alpha(V)beta(5) integrins. In preosteoblasts, Periostin acts as a cell adhesion molecule and plays a role in osteoblast recruitment, spreading and attachment. Periostin is mainly detected in lower gastrointestinal tract, aorta, stomach, placenta, uterus and breast tissues but is up-regulated in epithelial ovarian tumors and overexpressed in breast cancer. Expression of Periostin is increased by bone morphogenetic protein (BMP2) and transforming growth factor beta 1(TGF beta 1). Periostin contains a typical signal sequence, followed by a cysteine-rich domain, a fourfold repeated domain, which shows homology with the insect protein fasciclin, and a C-terminal domain.
仅用于科研。不用于诊断过程。未经明确授权不得转售。
生物信息学
蛋白别名: adhesion molecule; fasciclin I-like; Fasciclin-I like; MGC119510; MGC119511; OSF 2; OSF-2; osteoblast specific factor 2; osteoblast specific factor 2 (fasciclin I-like); Osteoblast-specific factor 2; periodontal ligament-specific periostin; Periostin; periostin, osteoblast specific factor; periostin-like factor; PN; RP11 412K4.1; RP11-412K4.1; unnamed protein product
基因别名: A630052E07Rik; AI747096; OSF-2; OSF2; PDLPOSTN; peri; PLF; PN; POSTN
UniProt ID: (Human) Q15063, (Mouse) Q62009
Entrez Gene ID: (Human) 10631, (Rat) 361945, (Mouse) 50706